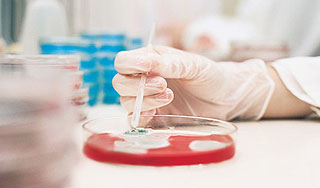
Ученые нашли "неубиваемую" бактерию Ученые нашли "неубиваемую" бактерию

10 октября, четверг | ![]() ![]() ![]() |
![]() | ПОЛИТИКА | ЭКОНОМИКА | ОБЩЕСТВО | ПРОИСШЕСТВИЯ | КУЛЬТУРА | СПОРТ | МЕДИА | В МИРЕ | АВТО | ТЕХНОЛОГИИ | ![]() |
| Фоторепортажи | Видеосюжеты | Комментарии | Погода | Работа | Форум | Карта | Подписка и RSS | Реклама| О газете |
Ученые нашли "неубиваемую" бактерию15 апреля 2011, пятница, 15:35 – БРЯНСК.RU | Комментарии: 0
| Версия для печати Супербактерия с геномом NDM-1, обнаруженная в Нью-Дели, способна расщеплять самые сильные антибиотики. Медики опасаются, что ее свойства передадутся опасным вирусам, которые станут еще более трудноизлечимыми.Геном был назван в честь столицы Индии, где он и был обнаружен впервые. Бактерии с NDM-1 были найдены в водопроводной воде, лужах и стоках Нью-Дели, сообщает сайт газеты "Труд". Из Индии супербактерии уже попали в Великобританию, Францию, Бельгию, США, Канаду и Австралию. На данный момент сама бактерия безвредна для человека. Опасение ученых вызывает то, что разрушительный ген способен легко передаваться новым бактериям, в том числе тем, которые вызывают серьезные заболевания. Например, это может привести к созданию новых устойчивых форм холеры и дизентерии. В изучении бактерии с геномом NDM-1 Индии обещала оказать помощь Всемирная организация здравоохранения. "Всемирная организация здравоохранения поможет индийскому правительству исследовать ген NDM-1 и выяснить, представляет ли супербактерия опасность для здоровья", – цитирует главу представительства ВОЗ Нату Манабде РИА Новости. Всемирная организация здравоохранения ранее уже выражала тревогу по поводу антимикробной резистентности, которая возникает благодаря злоупотреблению антибиотиками. Как уже писали Дни.Ру, в августе 2010 года бактерии с геномом NDM-1 были обнаружены в Великобритании. На тот момент было зафиксировано около 50 случаев заражения человека устойчивой к антибиотикам бактерией. Источник:
|
![]() | ПОЛИТИКА | ЭКОНОМИКА | ОБЩЕСТВО | ПРОИСШЕСТВИЯ | КУЛЬТУРА | СПОРТ | МЕДИА | В МИРЕ | АВТО | ТЕХНОЛОГИИ | ![]() |
| Фоторепортажи | Видеосюжеты | Комментарии | Погода | Работа | Форум | Карта | Подписка и RSS | Реклама| О газете |
| Размещение рекламы в газете БРЯНСК.RU: Прайс-лист, тел. (4832) 37-19-38, почта info@briansk.ru Для информационных писем в редакцию: news@briansk.ru | ![]() | ![]() | ||
| 2005–2015 © Ежедневная интернет-газета БРЯНСК.RU При цитировании активная ссылка на БРЯНСК.RU обязательна Материалы газеты могут содержать информацию 18+ | ![]() | Открыв данный сайт, Вы соглашаетесь с Правилами cайта (договор-оферта). Если вы не согласны с Правилами, немедленно покиньте сайт! | ![]() |

В глубине экрана: Мастер-класс по ремонту телевизоров
Погружение в мир футбола онлайн: для поклонников Игры
Займ без проверок
Тотализаторы: что это такое и чем они отличаются от обычных ставок?
Играть в бесплатные игровые автоматы в онлайн-клубе Вулкан
Стоит ли посещать офтальмолога при замене очков?
Успешные игроки предпочитают игровые автоматы Вулкан
Новое казино Супер Слотс поможет воплотить ваши мечты в реальность







ПОПУЛЯРНЫЕ МАТЕРИАЛЫ










